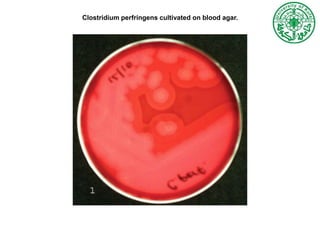
Clostridium perfringens cultivated on blood agar.

The document outlines the characteristics and pathogenicity of various Clostridium species, focusing on their morphology, toxin production, and diseases caused by them. It categorizes these bacteria into groups based on their toxin activity, including neurotoxic and histotoxic clostridia, and provides details on laboratory diagnosis methods. Additionally, it describes the significant clostridial diseases, primarily related to C. tetani, C. botulinum, C. perfringens, and C. difficile.